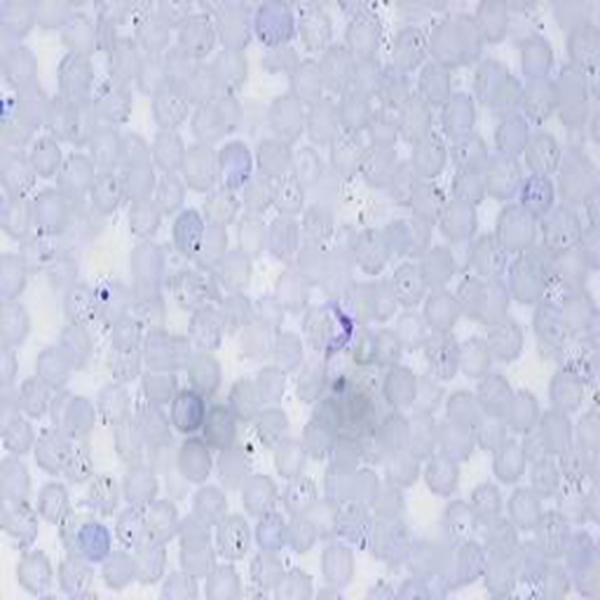
伊氏锥虫

伊氏锥虫形态图

寄生虫图片伊氏锥虫
图片尺寸450x242
十三伊氏锥虫病答案ppt18页
图片尺寸1152x864伊氏锥虫病
图片尺寸568x642
寄生虫图片伊氏锥虫
图片尺寸350x417
图4:无尽睡眠之虫——锥虫(trypanosoma)这种寄生虫大多分布在
图片尺寸700x466伊氏锥虫
图片尺寸600x600
伊氏锥虫(左)和马媾疫锥虫(右)
图片尺寸508x883
显微镜下的染色克氏锥虫
图片尺寸1024x482
美洲锥虫病走出恐狂症的最好方法
图片尺寸1080x711
《十三,伊氏锥虫病.ppt》
图片尺寸1152x864
锥虫体的详细影像学为抗击昏睡病的新机会铺平了道路
图片尺寸487x417锥虫属brucei寄生虫
图片尺寸1200x800
锥虫照片
图片尺寸612x467
锥体虫病
图片尺寸234x350
虫谱大观锥蝽的身世
图片尺寸980x552
锥体虫
图片尺寸220x156
锥虫属
图片尺寸383x300
面向世界科技前沿面向国家重大需求面向国民经济主战场
图片尺寸600x688
【疫病防治】棘球蚴病及其防治
图片尺寸243x566锥虫属brucei寄生虫
图片尺寸1200x800